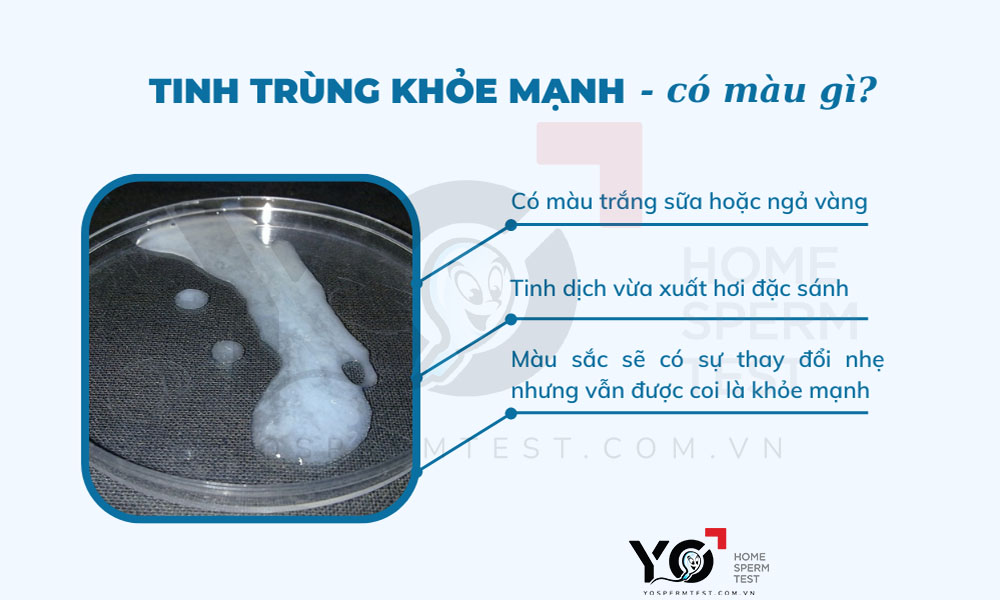

Physical Address
304 North Cardinal St.
Dorchester Center, MA 02124
Physical Address
304 North Cardinal St.
Dorchester Center, MA 02124

Tinh trùng là yếu tố quyết định quan trọng đến sức khỏe sinh sản của nam giới. Màu sắc của tinh trùng không chỉ phản ánh tình trạng sức khỏe tổng thể mà còn giúp nhận biết các dấu hiệu bất thường và nguy cơ mắc một số bệnh lý tiềm ẩn. Vậy tinh trùng màu gì là tốt? Như thế nào là bình thường và đâu là những màu sắc bất thường cần lưu ý? Trong bài viết này, chúng ta sẽ cùng tìm hiểu về màu sắc tinh trùng, dấu hiệu nhận biết tinh trùng khỏe mạnh, nguyên nhân gây tinh trùng có màu lạ cũng như cách cải thiện chất lượng tinh trùng và những lưu ý quan trọng khi quan sát màu sắc tinh trùng.
Tinh trùng khỏe mạnh thường có màu trắng đục hoặc trắng xám và độ sệt giống như trứng sống. Những đặc điểm này không chỉ phản ánh sức khỏe sinh sản mà còn cho thấy sự cân bằng trong cơ thể. Màu sắc bình thường của tinh dịch có thể dao động từ trắng đến hơi vàng nhạt nếu đã lâu không xuất tinh.
Nếu tinh dịch chuyển sang các màu như vàng đậm, xanh nhạt, nâu hay thậm chí có máu, đó có thể là dấu hiệu cảnh báo. Các màu sắc này thường liên quan đến các vấn đề sức khỏe tiềm ẩn và nên được kiểm tra. Điều quan trọng là tinh dịch khỏe mạnh thường có mùi nhạt, không dễ nhận biết, nhờ sự kết hợp của các hợp chất như axit citric và canxi.
Tuy nhiên, nếu tinh trùng có tính lỏng như nước hoặc vón cục, đây cũng là những dấu hiệu không bình thường mà bạn cần lưu ý. Một tinh trùng khỏe mạnh là yếu tố quan trọng để đảm bảo khả năng sinh sản, vì vậy hãy luôn quan tâm đến sức khỏe của bản thân.

Màu sắc của tinh dịch thường là một vấn đề khiến nhiều người băn khoăn. Theo các chuyên gia, tinh dịch được coi là bình thường khi có màu trắng đục hoặc hơi vàng nhạt. Thực tế, màu sắc này có thể thay đổi nhẹ, nhưng vẫn nằm trong giới hạn an toàn và không gây lo ngại.
Màu trắng đục hoặc trắng xám thường được xem là dấu hiệu cho thấy tinh dịch khỏe mạnh, trong khi màu vàng nhạt cũng không phải là vấn đề nghiêm trọng, đặc biệt nếu bạn đã lâu chưa xuất tinh. Tuy nhiên, nếu tinh dịch có dấu hiệu bất thường như màu đỏ hay xanh, bạn nên tham khảo ý kiến bác sĩ vì đây có thể là dấu hiệu của một số vấn đề sức khỏe.
Ngoài màu sắc, mùi của tinh dịch cũng khá bình thường, thường nhẹ nhàng do sự kết hợp của vài thành phần. Vì vậy, nếu bạn thấy tinh dịch có màu trắng sữa, hơi đục và có mùi nhạt, đó là trạng thái hoàn toàn bình thường. Hãy yên tâm và chú ý đến sức khỏe chung của cơ thể mình nhé!

Khi nói đến chất lượng tinh trùng, có nhiều yếu tố bạn cần chú ý để nhận biết tinh trùng có khỏe hay không. Đầu tiên, màu sắc của tinh dịch là một chỉ số quan trọng. Tinh dịch khỏe mạnh thường có màu trắng đục hoặc hơi xám, nếu bạn thấy màu vàng sậm hay màu nâu, đặc biệt nếu có lẫn máu, đó có thể là dấu hiệu của vấn đề sức khỏe.
Mùi của tinh dịch cũng đóng vai trò không kém. Tinh dịch khỏe mạnh thường có mùi nhẹ, đặc trưng, không hôi hoặc quá nặng. Độ nhớt và thể tích của tinh dịch cũng phản ánh quá trình sản xuất tinh trùng. Tinh dịch lý tưởng sẽ có độ nhớt vừa phải và không vón cục, nếu bạn thấy những hạt trắng nhỏ, có thể tinh dịch đã không đạt tiêu chuẩn.
Cuối cùng, hình dạng và khả năng di chuyển của tinh trùng là những yếu tố quyết định khả năng sinh sản. Tinh trùng khỏe mạnh thường có đầu hình oval, đuôi dài và di chuyển mạnh mẽ. Điều này không chỉ ảnh hưởng đến khả năng thụ thai mà còn đến sự phát triển của thai nhi trong tương lai. Việc duy trì một lối sống lành mạnh sẽ giúp bạn bảo vệ sức khỏe tinh trùng của mình.

Màu sắc của tinh dịch là một yếu tố quan trọng giúp chúng ta đánh giá sức khỏe sinh sản của nam giới. Tinh dịch bình thường có màu trắng đục hoặc xám, mang lại cảm giác lành mạnh. Tuy nhiên, khi thấy tinh dịch có màu sắc bất thường như vàng hoặc xanh, đây có thể là dấu hiệu của tình trạng viêm nhiễm hoặc nhiễm khuẩn đường sinh dục.
Không chỉ dừng lại ở màu vàng, tinh dịch có thể xuất hiện những màu sắc khác như đỏ hoặc nâu, cho thấy có máu trong tinh dịch. Điều này không thể xem nhẹ, vì nó có thể là biểu hiện của các vấn đề sức khỏe nghiêm trọng. Đôi khi, màu sắc có thể bị ảnh hưởng bởi chế độ ăn uống hoặc thói quen sinh hoạt, như việc tiêu thụ rượu.
Mặc dù nhiều màu sắc bất thường chỉ là tạm thời và không gây hại, nhưng nếu bạn nhận thấy sự thay đổi kéo dài, hãy nhớ rằng việc thăm khám bác sĩ luôn là lựa chọn sáng suốt để bảo vệ sức khỏe của bản thân. Hãy lắng nghe cơ thể và chăm sóc mình nhé!

Màu sắc của tinh dịch có thể phản ánh sức khỏe sinh sản của nam giới, và việc tinh dịch có màu lạ thường là dấu hiệu cần chú ý. Tinh dịch màu xanh lá cây thường cảnh báo về tình trạng viêm nhiễm đường tiết niệu hoặc các bệnh lây truyền qua đường tình dục, kèm theo triệu chứng như tiểu dắt và đau bụng. Nếu tình trạng này kéo dài, có thể liên quan đến giãn tĩnh mạch thừng tinh, một vấn đề không hề đơn giản.
Ngoài ra, tinh dịch màu vàng hoặc vàng xanh có thể do nhiễm trùng tuyến tiền liệt. Vi khuẩn từ đường tiết niệu có thể xâm nhập vào tuyến này, gây ra tình trạng viêm nhiễm. Đáng lưu ý, những bệnh mãn tính như viêm gan hay rối loạn máu đông cũng có thể ảnh hưởng đến màu sắc của tinh dịch.
Thậm chí, tinh dịch có màu nâu đỏ có thể báo hiệu viêm nhiễm hoặc chảy máu ở tuyến tiền liệt. Những hiện tượng này không chỉ gây lo lắng mà còn cần được kiểm tra y tế kịp thời để xác định nguyên nhân và có biện pháp điều trị hợp lý.

Quyết định thời điểm đi khám bác sĩ thật sự rất quan trọng và có thể thay đổi tùy thuộc vào từng trường hợp cụ thể. Đầu tiên, chúng ta cần xem xét việc khám định kỳ. Các chuyên gia khuyên rằng, người lớn nên đi khám sức khỏe định kỳ từ 6 tháng đến 1 năm một lần, đặc biệt là đối với phụ nữ cần kiểm tra sức khỏe phụ khoa.
Ngoài ra, có những dấu hiệu cần chú ý hơn. Nếu bạn gặp gỡ triệu chứng như giảm cân không rõ nguyên nhân, sốt kéo dài hoặc tình trạng mệt mỏi, đau nhức cơ thể mà không có lý do cụ thể, hãy nhanh chóng đến bác sĩ để được khám và tư vấn. Đừng quên theo dõi sức khỏe của trẻ nhỏ. Nếu bé có dấu hiệu như khó thở, khóc bất thường, hoặc thèm ăn ít, cha mẹ nên đưa trẻ đến bác sĩ nhi ngay lập tức.
Đặc biệt, trong những trường hợp khẩn cấp như đau dữ dội ở vùng bụng hoặc tình trạng chóng mặt liên tục, việc tìm kiếm sự chăm sóc y tế kịp thời là cực kỳ cần thiết. Hãy nhớ rằng, sức khỏe là tài sản quý giá nhất của chúng ta!
Cải thiện chất lượng tinh trùng là một quá trình cần sự kiên nhẫn và chú trọng đến nhiều khía cạnh trong lối sống. Đầu tiên, chế độ dinh dưỡng hợp lý đóng vai trò quan trọng. Bạn nên bổ sung các thực phẩm giàu vitamin như B, C, D, E và kẽm từ hải sản, thịt đỏ, hạt giống để cung cấp dưỡng chất cần thiết cho cơ thể.
Ngoài ra, tập luyện thể dục thể thao đều đặn giúp cải thiện sức khỏe tổng quát và tăng cường lưu thông máu đến các cơ quan sinh sản. Hãy dành ít nhất 30 phút mỗi ngày để hoạt động, như đi bộ, chạy bộ hay tham gia các môn thể thao yêu thích. Đặc biệt, việc duy trì cân nặng hợp lý cũng rất quan trọng; giảm cân nếu cần thiết sẽ giúp cải thiện chất lượng tinh trùng đáng kể.
Bạn cũng nên tránh xa rượu bia, thuốc lá và các chất kích thích khác. Chúng không chỉ ảnh hưởng đến sức khỏe tổng quan mà còn làm giảm khả năng sinh sản. Cuối cùng, hãy đảm bảo bạn có đủ thời gian nghỉ ngơi và thư giãn để giảm căng thẳng, tạo điều kiện tốt nhất cho cơ thể phát triển. Chỉ cần một chút chú ý và thay đổi tích cực, bạn sẽ thấy sự khác biệt rõ rệt trong chất lượng tinh trùng của mình!

Khi quan sát màu sắc của tinh trùng, điều đầu tiên cần lưu ý là màu sắc bình thường thường là trắng đục hoặc trắng sữa. Tuy nhiên, nếu tinh dịch có màu nâu, đỏ, hay đôi khi chỉ là hồng nhạt, rất có thể là do sự xuất hiện của tế bào máu, tình trạng này gọi là xuất tinh ra máu. Điều này đáng lo ngại và có thể chỉ điểm đến một số vấn đề sức khỏe nghiêm trọng.
Dù tinh dịch có màu sắc bình thường, nam giới vẫn cần chú ý đến chất lượng tinh trùng bên trong. Nếu tinh trùng có bất thường về mặt sinh học, vấn đề vô sinh có thể xảy ra. Màu sắc tinh dịch bất thường đôi khi chỉ là tạm thời và lành tính, nhưng cũng có thể là dấu hiệu của bệnh lý, như nhiễm trùng hoặc viêm tinh hoàn.
Trong trường hợp thấy màu sắc khác thường, việc thực hiện kiểm tra sức khỏe là rất cần thiết. Nam giới nên chú ý đến các dấu hiệu đi kèm như số lượng tinh trùng thấp, hình dạng tinh trùng hay khả năng di động. Những điều này sẽ giúp bạn hiểu rõ hơn về sức khỏe sinh sản của bản thân.

Kết luận, màu sắc của tinh trùng không chỉ ảnh hưởng đến sức khỏe sinh sản mà còn phản ánh nhiều vấn đề về sinh lý của nam giới. Tinh trùng khỏe mạnh thường có màu trắng đục hoặc hơi ngà, trong khi màu sắc bất thường có thể chỉ ra sự thiếu hụt dinh dưỡng hoặc các vấn đề y tế nghiêm trọng hơn. Việc duy trì một lối sống lành mạnh, chế độ ăn uống hợp lý và khám sức khỏe định kỳ là rất cần thiết để cải thiện chất lượng tinh trùng. Đầu tư vào sức khỏe sinh sản không chỉ mang lại lợi ích cho bản thân mà còn cho sự phát triển của thế hệ tương lai.